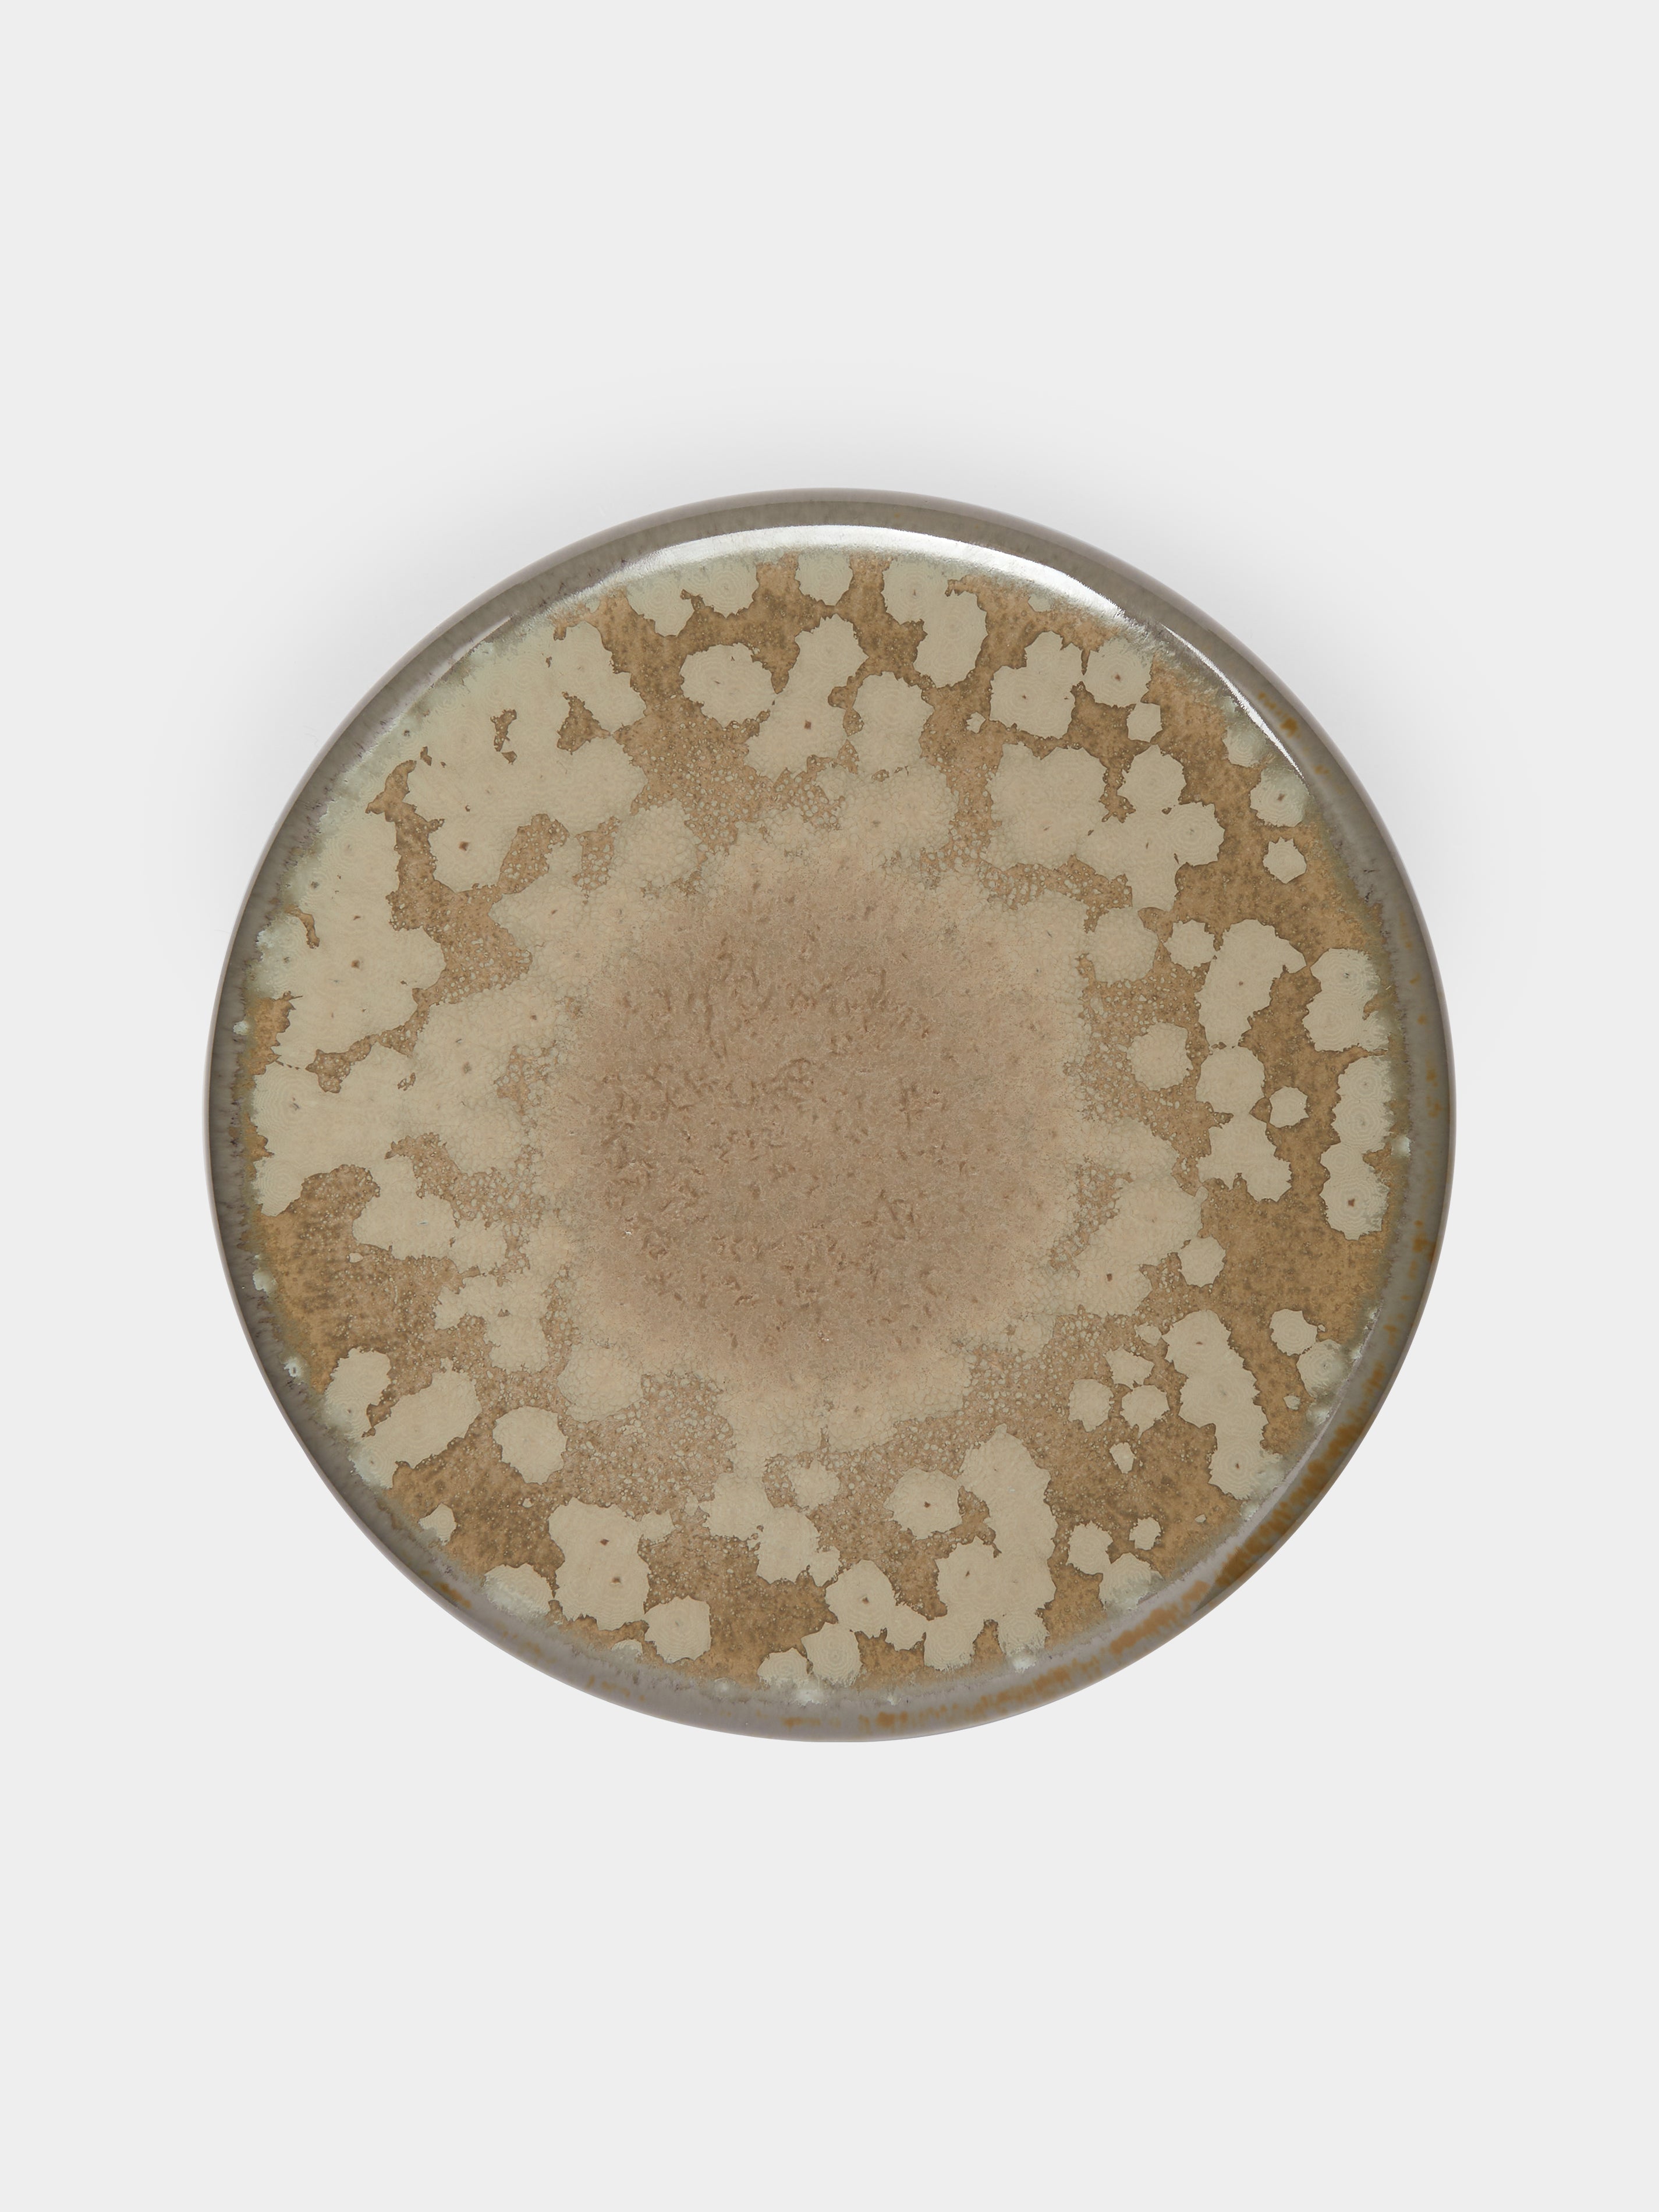

Jaune de Chrome Basmati Bubble Porcelain Plate (6.5in/16.5cm)
$182
All taxes and duties included; we guarantee no additional charges on delivery.
- Color: Beige
- Material: Ceramic
- Dimensions: 16.5cm (d) / 6" (d)
- Care: Hand wash only
- Country of origin: France
- Product ID: 2202302019
View more from: Jaune de Chrome / Dessert, salad & side plates
All taxes and duties included; we guarantee no additional charges on delivery.
- Color: Beige
- Material: Ceramic
- Dimensions: 16.5cm (d) / 6" (d)
- Care: Hand wash only
- Country of origin: France
- Product ID: 2202302019
View more from: Jaune de Chrome / Dessert, salad & side plates

Meet the Maker:
Jaune de Chrome
Two hundred years ago, Christian Le Page and Catherine Badaire taught themselves an extreme-heat glazing process that infuses their earthenware with metallics – an alchemical melding of elements creating spontaneous speckles and starbursts. Not merely eye-catching, their collection of fine Limoges porcelain, created in limited distribution, coaxes you in for closer scrutiny.